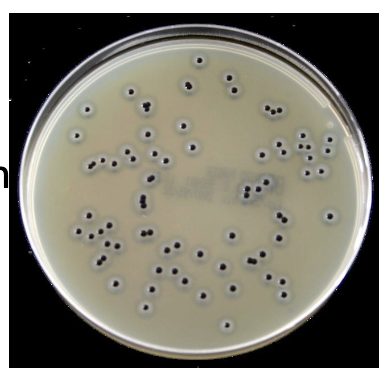
<ul><li><p><strong>S. aureus</strong> → black colonies + clearing (enzyme activity)</p></li><li><p>Others inhibited or atypical → lack these enzymes</p></li></ul><p></p>
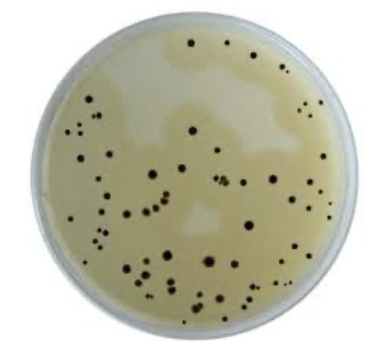
<ul><li><p><strong>Sodium metabisulphite + ammonium ferric citrate</strong> → H₂S indicator</p></li><li><p><strong>Antibiotics (polymyxin, sulphadiazine, oleandomycin)</strong> → selectivity</p></li><li><p><strong>Yeast for growth promotion</strong></p></li></ul><p></p>
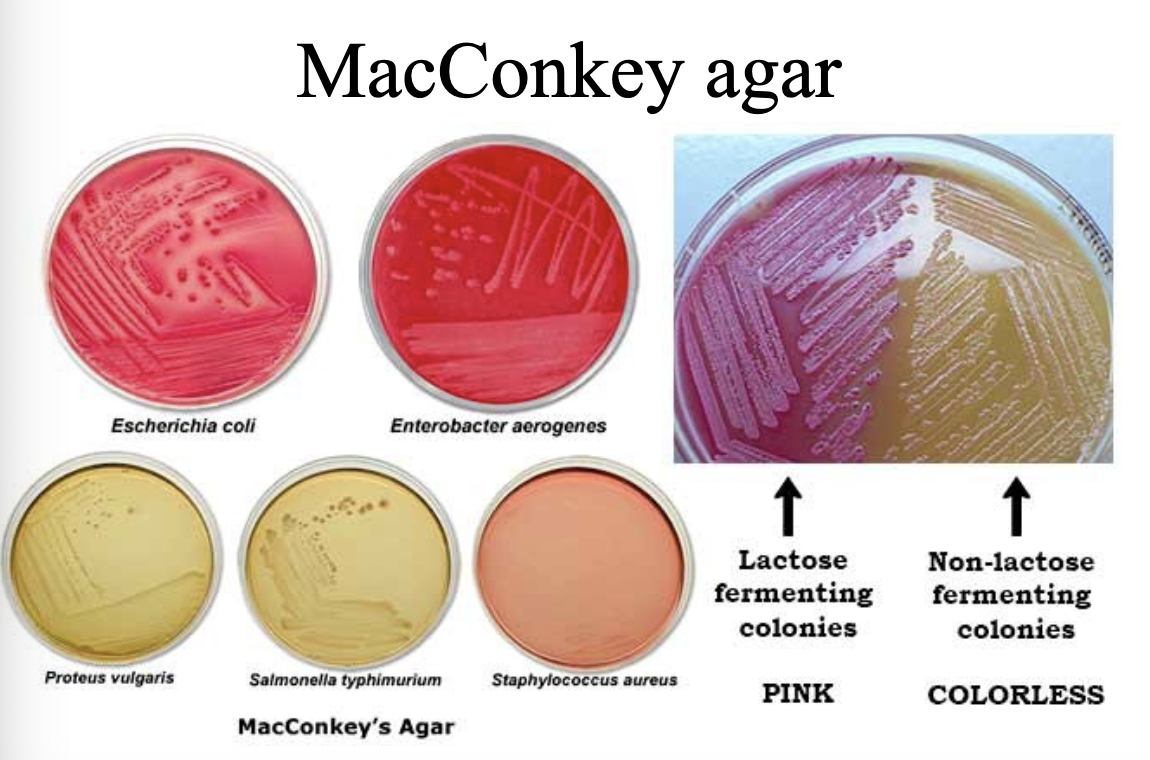
<p>Differentiates <strong>lactose fermenters vs non-fermenters</strong> and selects for Gram-negative bacteria </p><p><u>Inhibits Gram-positive organisms</u> by bile salts and crystal violet. </p>
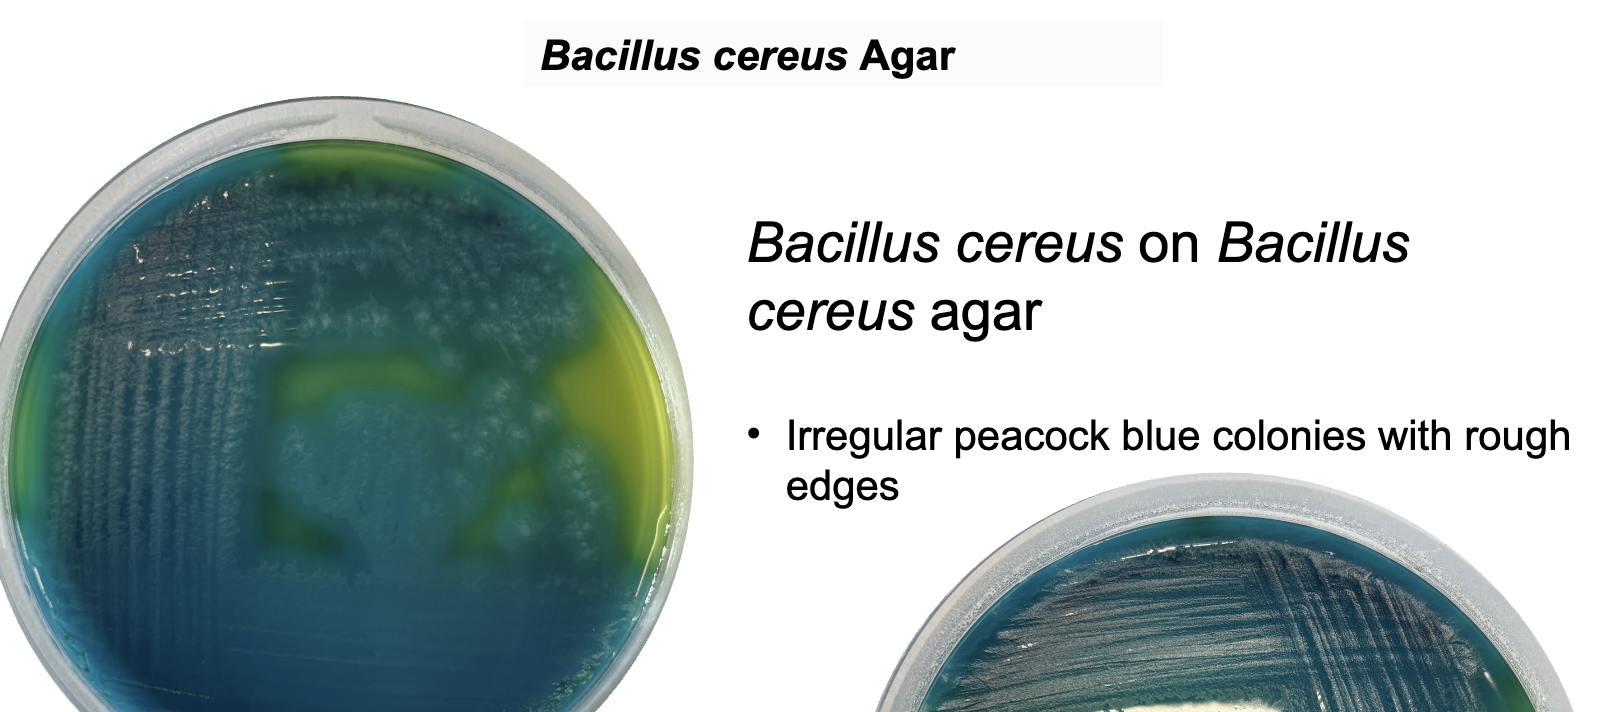
<p>Selective + differential medium detecting <strong>mannitol fermentation and lecithinase activity</strong>.</p><p>Inhibits most bacteria except Bacillus spp.</p>
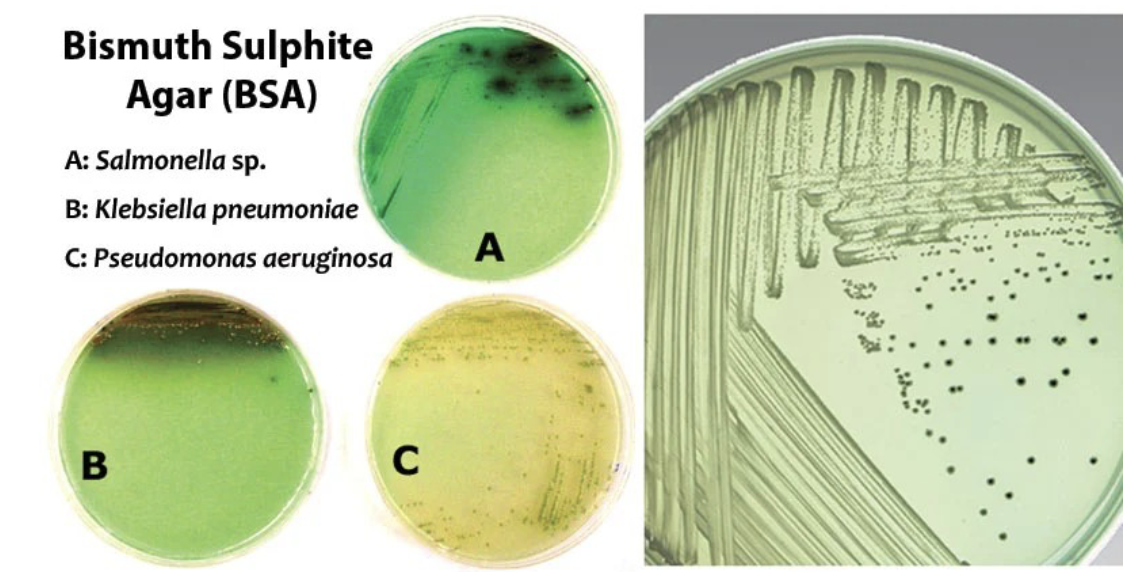
<p>Bismuth Sulphite Agar is used for the selective isolation and differentiation of enteric pathogens, <strong>particularly Salmonella species,</strong> <strong>by <u>inhibiting the growth of Gram-positive bacteria </u>and indicating </strong>H₂S<strong> production through black colony formation.</strong></p><p><strong>→ </strong>Strong inhibition of coliforms and Gram positives</p>
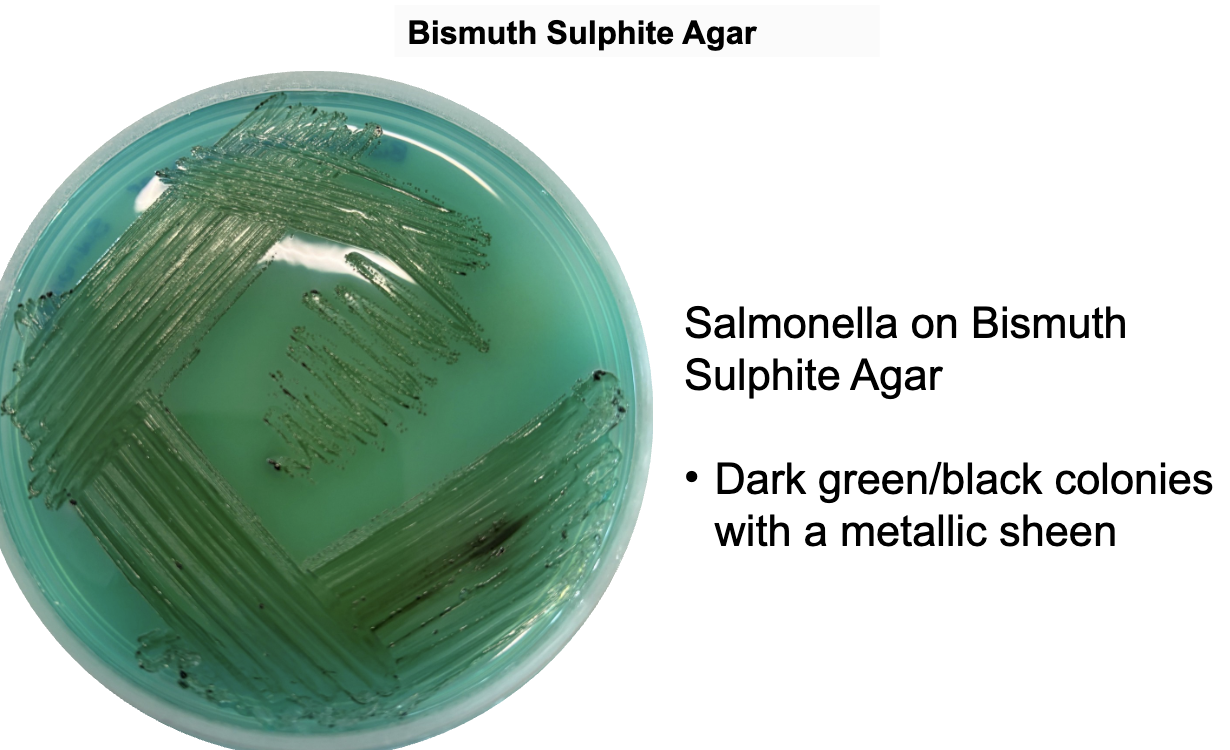
<ul><li><p><strong>Bismuth sulphite + brilliant green</strong> → selective, suppresses coliforms</p></li><li><p><strong>Iron salts</strong> → stain colonies in presence of H₂S </p></li><li><p><strong>Sulphur compounds as a substrate</strong> → H₂S production</p></li></ul><p></p>
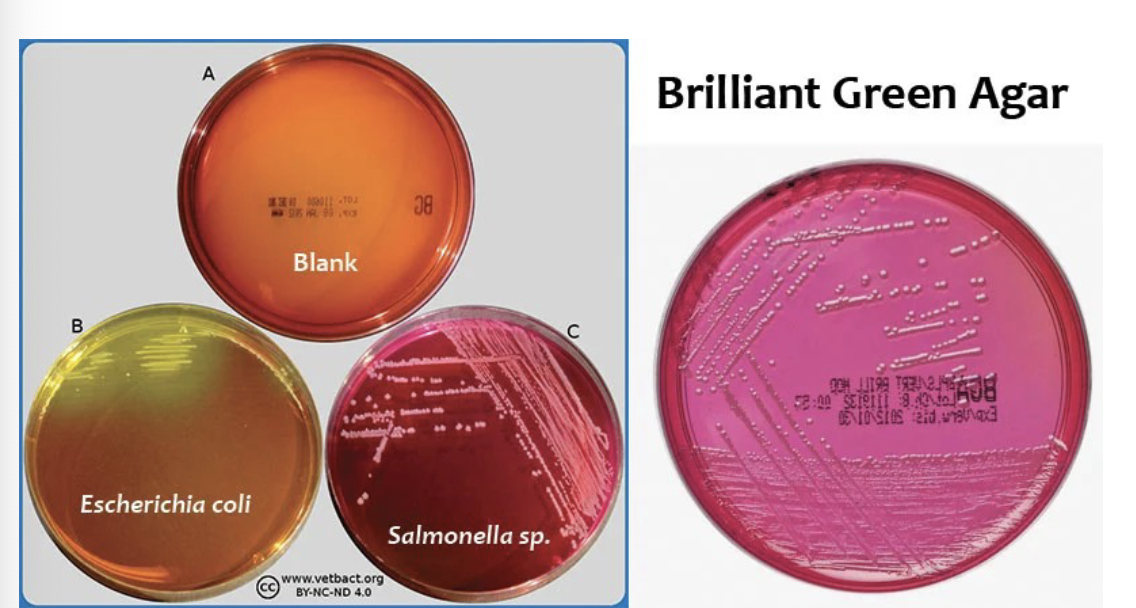
<p>Contains brilliant green dye that inhibits gram-positive bacteria, allowing for the selective growth of enteric gram-negative bacteria such as <em>Salmonella</em> (except <em>S. typhi) </em>and <em>Shigella</em> <strong>using dye inhibition and sugar fermentation.</strong></p>
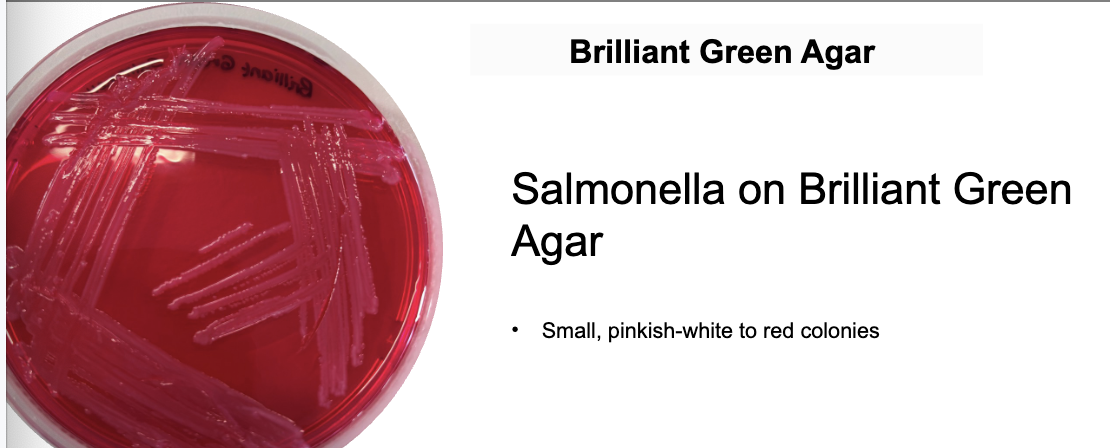
<p><strong>Salmonella → red/pink colonies (non-fermenters)</strong></p><p><strong>S.typhimurium → red colonies</strong></p><p></p>
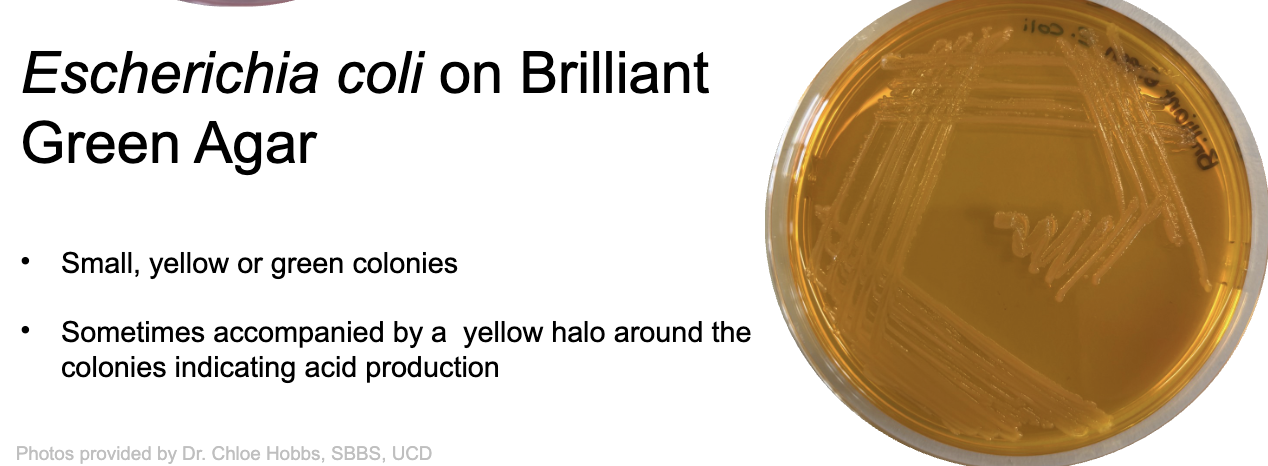

Practical flashcards
1/70
There's no tags or description
Looks like no tags are added yet.
Name | Mastery | Learn | Test | Matching | Spaced | Call with Kai |
|---|
No analytics yet
Send a link to your students to track their progress
71 Terms
What is the principle of Lysine Decarboxylase Broth?
Detects the ability of organisms to decarboxylate lysine → cadaverine (amine and CO2), producing an alkaline reaction after initial glucose fermentation.
Not selective; diagnostic only.

What is the method of Lysine Decarboxylase Broth?
Inoculate broth
Incubate ~24h at 35°C
Yellow → initial acid from glucose
Purple → lysine decarboxylation (positive)
Key ingredients & role of Lysine Decarboxylase Broth?
Glucose → acid production (initial)
Lysine → substrate
Bromocresol purple → pH indicator
Yeast extract → nutrients
No peptone → prevents false positives
Organisms detected by lysine decarboxylase results & why?
Salmonella spp. → positive (decarboxylate lysine)
Shigella, Citrobacter → negative yellow coloured broth
Klebsiella pneumoniae → positive reaction
Helps differentiate Enterobacteriaceae based on enzyme presence
Baird-Parker Agar principle?
Selective + differential medium for Staphylococcus aureus, based on tellurite reduction + lecithinase activity
Inhibits most bacteria except staphylococci, using glycine, lithium and tellurite
Baird-Parker Agar method?
Plate sample
Incubate 24–48h
Look for black shiny colonies + clear zone
Key ingredients of BP agar?
Tellurite → reduced to black colonies
Egg yolk → detects lecithinase/lipase
Lithium chloride + glycine → selective agents
Sodium pyruvate → recovery of damaged cells
Organisms detected by BP agar & why?
S. aureus → black colonies + clearing (enzyme activity)
Others inhibited or atypical → lack these enzymes
Perfringens Agar Principle?
Detects sulphite reduction → black colonies under selective conditions.
Inhibits most non-target bacteria including Salmonella and staphylococci.
Method behind Perfringens agar?
Pour plate
Anaerobic incubation at 42ºC
Black colonies = presumptive positive
Key ingredients of Perfringens agar?
Sodium metabisulphite + ammonium ferric citrate → H₂S indicator
Antibiotics (polymyxin, sulphadiazine, oleandomycin) → selectivity
Yeast for growth promotion
Organisms detected by Perfringens agar & why?
Clostridium perfringens → reduces sulphite → black colonies
MacConkey Agar Principle?
Differentiates lactose fermenters vs non-fermenters and selects for Gram-negative bacteria
Inhibits Gram-positive organisms by bile salts and crystal violet.
Key ingredients of MacConkey agar?
Lactose → fermentable sugar
Neutral red → pH indicator
Bile salts → inhibit Gram positives
Results on MacConkey agar:
E. coli → pink (lactose fermenter)
Salmonella → colourless (non-fermenter)
Shigella → colourless (non-fermenter)
Tetrathionate Broth Principle?
Enrichment medium selecting for bacteria with tetrathionate reductase enzyme.
This broth enhances the recovery of Salmonella and Proteus from fecal samples and other sources, while suppressing coliforms.
Tetrathionate Broth method?
Inoculate specimen
Incubate 18–24h
Subculture to selective agar i.e. Bismuth sulfite and Brilliant green agar
Tetrathionate Broth Key ingredients?
Thiosulphate + iodine → tetrathionate
Bile salts → inhibit non-enterics
Calcium carbonate → neutralises toxicity
What organisms are enriched by tetrathionate broth and why?
Used to enrich Salmonella and Proteus species due to their ability to utilize tetrathionate as a terminal electron acceptor, facilitating their growth while inhibiting competing microorganisms.
E. coli inhibited
Inhibit Proteus with novobiocin
Bacillus cereus Selective Agar (PEMBA) Principle?
Selective + differential medium detecting mannitol fermentation and lecithinase activity.
Inhibits most bacteria except Bacillus spp.
Bacillus cereus Selective Agar Method?
Plate sample
Incubate
Colony appearance, precipitation of hydrolysed lecithin and the failure of Bacillus cereus to utilise mannitol
Bacillus cereus Selective Agar Key ingredients?
Mannitol + bromothymol blue → pH indicator
Egg yolk → lecithinase detection
Polymyxin B → selective agent
What is the typical colony morphology of B. cereus on Bacillus cereus Selective Agar and why?
Typically, B. cereus exhibits blue colonies with a surrounding precipitate due to lecithinase activity, indicating a lack of mannitol fermentation.
Bismuth Sulphite Agar Principle?
Bismuth Sulphite Agar is used for the selective isolation and differentiation of enteric pathogens, particularly Salmonella species, by inhibiting the growth of Gram-positive bacteria and indicating H₂S production through black colony formation.
→ Strong inhibition of coliforms and Gram positives
Bismuth Sulphite Agar Method?
Plate directly or after enrichment
Incubate 18–48h at 37°C under aerobic conditions.
Observe for black colonies.
Bismuth Sulphite Agar Key ingredients?
Bismuth sulphite + brilliant green → selective, suppresses coliforms
Iron salts → stain colonies in presence of H₂S
Sulphur compounds as a substrate → H₂S production
what is the Typical colony morphology for Salmonella typhi. on Bismuth sulfite agar?
Typical morphology includes smooth, round, and may appear black, with a metallic sheen due to H₂S production.
Brilliant Green Agar Principle?
Contains brilliant green dye that inhibits gram-positive bacteria, allowing for the selective growth of enteric gram-negative bacteria such as Salmonella (except S. typhi) and Shigella using dye inhibition and sugar fermentation.
Brilliant Green Agar Key ingredients?
Brilliant green → inhibits Gram positives & many Gram negatives
Lactose/sucrose → differentiation
Phenol red → indicator
Agar → solidifying agent
Peptones → nutrient source
Typical colony morphology of Salmonella on brilliant green agar?
Salmonella → red/pink colonies (non-fermenters)
S.typhimurium → red colonies
Typical colony morphology of E. coli, Proteus, Pseudomonas on brilliant green agar?
E. coli → yellow colonies (fermenters) due to lactose fermentation, contrasting with non-fermenters like Salmonella.
Proteus, Pseudomonas → small red colonies
Triple Sugar Iron (TSI) Agar Principle?
Differentiates Enterobacteriaceae by sugar fermentation + H₂S production + gas.
TSIA Method?
Stab butt + streak slant
Incubate
Interpret colours in butt/slant i.e. red indicates peptone alkylation, yellow indicates acid production by sugar fermentation
Gas production indicated by bubble in butt/cracks in the agar in slant

An alkaline/acid (K/A) (red slant/yellow butt) reaction =
It is indicative of glucose fermentation only
•An acid/acid (yellow slant/yellow butt) reaction:
It indicates the fermentation of glucose, lactose and/or sucrose.
•An alkaline/alkaline (red slant, red butt) reaction:
Absence of carbohydrate fermentation results.
Blackening of the medium in TSIA occurs in =
Occurs in the presence of H2S
Gas production
Bubbles or cracks in the agar indicate the production of gas (formation of CO2 and O2)
TSIA Key ingredients?
Glucose, lactose, sucrose
Phenol red → pH indicator
Thiosulphate + iron → H₂S detection
Peptones used as nitrogen source
What results do common organisms show with TSIA?
Common organisms show results such as yellow slants and butts for glucose fermenters, red slants for non-fermenters, and black precipitate for H₂S producers.
Specific reactions help identify bacteria like Salmonella and Shigella.

Urea Broth Principle?
Detects urease enzyme → urea → ammonia → alkaline pH.
Distinguishes urease-positive bacteria e.g. Proteus from urease-negative ones like Salmonella
Key ingredients in urea broth?
Urea
Phenol red as pH indicator
Nutrients for bacterial growth
DNase Agar Principle?
Detects DNase enzyme → DNA hydrolysis → clear zones.
Indicative of pathogenic S. aureus / streptococci and other DNase-producing bacteria.
Positive reactions show the ability to degrade DNA, distinguishing pathogenic strains.
DNase Agar Method?
Grow colonies
Add HCl → DNA precipitates
Clear zone in the agar around colonies. = DNase +
What is the coagulase test?
A laboratory test used to differentiate Staphylococcus aureus from other staphylococci by detecting the presence of coagulase enzyme, which causes blood plasma to clot.
A positive result indicates pathogenic potential.

MRS Agar Principle?
Selective for lactic acid bacteria via low pH and nutrient-rich conditions.
MRS agar Method?
Inoculate the agar with the sample
Incubate at 30°C for 48 hours
Observe for growth of lactic acid bacteria.
Inhibits many non-lactic bacteria via low pH + acetate.
Key ingredients of MRS agar?
Glucose → energy
Sodium acetate and ammonium citrate → inhibits competitors like moulds + streptococci
Citrate, Mg²⁺, Mn²⁺ → growth factors
What organisms grow on MRS agar & why?
Lactobacillus, Streptococcus, Pediococcus → tolerate acidic, enriched conditions
What is titratable acidity?
A measure of the total acidity i.e. lactic acid in a solution that can be neutralized by a base, often used in food and beverage analysis to assess quality and fermentation progress.
How was the % lactic acid found?

What is the delvo test?
Works by testing the presence of inhibitors such as antibiotics in milk, by the use of ampoules and plates which contain a culture medium containing a standardised number of spores from the thermophilic bacteria Geobacillus stearothermophilus, where the indicator (bromocresol purple) changes based on the bacteria’s metabolic activity, where the conditions favour their germination and growth, i.e. at 64ºC.

What is the MPN test for coliforms in water?
Presumptive test for faecal coliforms, i.e. lactose-fermenting, acid and gas-producing, rod-shaped facultative anaerobes like members of the Escherichia and Klebsiella families
Statistical method, a multi-step assay based on presumptive, confirmed and completed phases, where various volumes of serial dilutions of a chosen sample, i.e. water, are inoculated into large and small fermentation tubes containing broth media, e.g. MacConkey broth and then incubated at 37ºC for 48 hours
What is a positive / negative result indicated by in the MPN test for coliforms in water?
+ve = observation of gas production in any of the tubes after 24h
-ve= absence of gas after 48h is a negative test, where then a MPN table can be used to assess the MPN of organisms per 100mL of a sample
What is membrane filtration used for in food safety assessments?
Membrane filtration is a quantitative technique in screening the safety of water samples, i.e. used for food manufacturing or in beverages by passing the sample through a membrane filter that captures bacteria, which are then transferred to culture media for growth and identification.
allows for rapid results, i.e. within 24h when examining liquid samples for faecal bacterial contamination

What does the examination of filters with an immersion oil allow for?
Allows for microscopic inspection of adherent microbes to the surface, which, when a fluorescent antibody is used, allows for pathogen identification.
The membrane can also be transferred onto selective media e.g. mENDO agar, which permeates the membrane, allowing for easily countable single colonies to be grown, allowing for further identification.
What is the methylene blue test?
A method to assess milk quality by measuring the speed of reduction of methylene blue dye by a bacterial population :
High-quality milk retains the blue colour due to no reduction of the dye taking place by a lack of microbes capable of dehydrogenation
Milk of poor quality rapidly undergoes decolourisation i.e. within 2 hours of adding the dye, due to dehydrogenase activity of the bacterial population in the milk


Chemical principle behind methylene blue test
As pathogenic/ contaminant microbes can oxidise substrates via the removal of hydrogen using enzymes called dehydrogenases, the activity of such dehydrogenases can be determined by looking at the reduction of the methylene blue dye, which acts as a hydrogen acceptor for the microbial dehydrogenase.
Thus, if it goes from its oxidised state to a reduced one, a colour change is seen
High quality milk =
Not decolourised in 8 hours
Good quality milk =
Decolourised in 8 hours but not 6 hours
Fair milk =
Decolourised in 6 hours but not 2 hours
Poor milk =
Decolourised in 2 hours or less
What is the phosphatase test?
Used to determine the efficiency of the pasteurisation process as it is based on the property of the heat-labile enzyme present in raw milk which gets inactivated by heat treatment such as pasteurisation, where it assesses the enzyme’s ability to free the colourless compound p-nitrophenol (p-NP) from the yellow-coloured anion, p-nitrophenylphosphate (p-NPP)
What piece of equipment is used in the phosphatase test to assess pasteurisation?
A Lovibond Comparator is used to measure the increase in the amount of yellow colour produced based on the enzymatic cleavage of phosphate from p-NPP by phosphatase
How do we interpret results of the phosphatase test?

Pour plate vs spread plate technique:
These are methods for inoculating microbes onto agar plates.
In the pour plate technique, diluted microbial samples are mixed with molten agar and poured into a petri dish,
In the spread plate technique, a diluted microbial sample is spread evenly across the surface of the agar using a hockey stick spreader.
Pour plate vs spread plate advantages:
The pour plate technique allows for the isolation of anaerobic and aerobic organisms, while the spread plate technique provides more accurate quantification of colony-forming units (CFUs) on the surface.
Spread plate calculation:
i.e. if using a 0.1 mL volume:
Average x 10n x 10 = CFU/ml or CFU/g
e.g. n is the DF e.g. 10-2 = 102
Pour plate calculation:
i.e. if using a 1 mL volume:
Average x 10n x 1 = CFU/ml or CFU/g
Why are LAB used used in a variety of fermented food products such as yoghurt?
As they produce lactic acid as a fermentation product, and are aerotolerant, Gram-positive, non-respiring microbes that don’t produce spores and enhance the flavor and texture of food.
What is the symbiotic event between L. bulgaricus and S. thermophilus in yoghurt?
Key acidic molecules such as pyruvic acid, formic acid and CO2 are released into milk by S. thermophilus, which promotes the growth of L. bulgaricus, allowing it to produce peptides by protease action, amino acids and lactic acid, which promote the further growth of S. thermophilus, demonstrating the symbiotic relationship between the organism